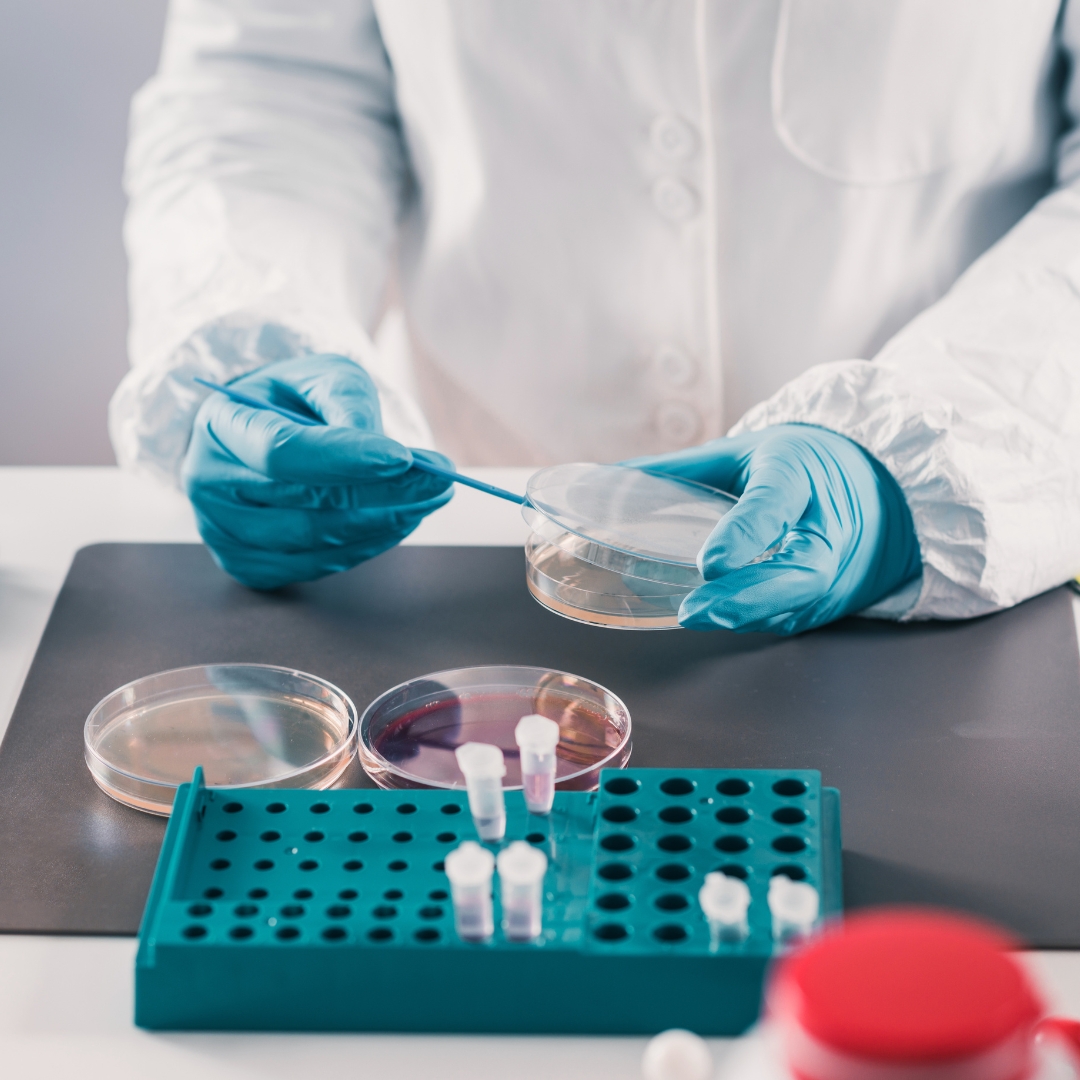

Ο οικογενειακός ιατρός είναι ένας γενικός ιατρός που παρέχει πρωτοβάθμια φροντίδα υγείας σε ασθενείς όλων των ηλικιών, από βρέφη έως ηλικιωμένους. Ο κύριος ρόλος του είναι να διαγνώσει, να θεραπεύει και να προλαμβάνει νόσους και προβλήματα υγείας, καθώς και να παρέχει προληπτικές συμβουλές και εκπαίδευση στους ασθενείς του. Συχνά ο οικογενειακός ιατρός αναλαμβάνει τον ρόλο του συντονιστή της φροντίδας υγείας για τους ασθενείς του, καθοδηγώντας τους προς ειδικούς ιατρούς ή εξειδικευμένες υπηρεσίες όταν απαιτείται.

Ο καρδιολόγος είναι ένας ιατρός που εξειδικεύεται στη διάγνωση, την πρόληψη και την αντιμετώπιση παθήσεων που αφορούν την καρδιά και τον κυκλοφορικό σύστημα. Αναλαμβάνει τη φροντίδα ασθενών με καρδιακές παθήσεις όπως καρδιακή ανεπάρκεια, καρδιακή αρρυθμία, καρδιαγγειακή νόσο και υπέρταση, και παρέχει διαγνωστικές εξετάσεις όπως ηλεκτροκαρδιογράφημα, ενδοκαρδιακές εξετάσεις, καρδιολογικές εξετάσεις επιτάχυνσης και άλλες εξετάσεις εικόνας για την αξιολόγηση της καρδιακής λειτουργίας. Ο καρδιολόγος συχνά συνεργάζεται με άλλους ιατρούς και εξειδικευμένους επαγγελματίες υγείας για την ολοκληρωμένη φροντίδα των ασθενών του.
Phasellus laoreet tristique sagittis. Phasellus commodo dolor sed elit iaculis interdum.
Suspendisse sed lorem elit. Aenean nec faucibus lacus. Phasellus ultrices risus vitae eros suscipit pellentesque.
Etiam ante ante, molestie vitae cursus ac, pharetra euismod libero.
Mauris vitae varius tortor. Fusce eros diam, auctor sit amet lorem ut, efficitur iaculis magna. Vivamus bibendum.